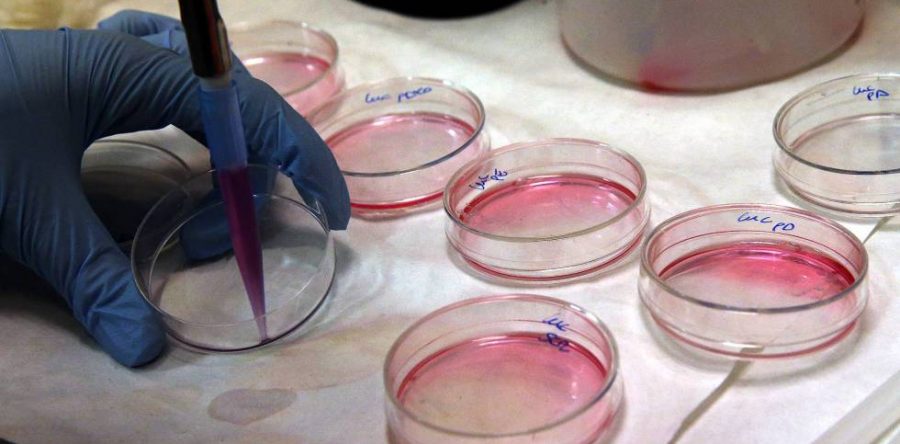
Descubren fármaco contra el cáncer que no daña células sanas

Científicos de Malbourne, Australia descubrieron un nuevo tipo de fármaco contra el cáncer que puede poner a 'dormir' de forma permanente las células cancerosa, deteniendo su crecimiento y diseminación por el organismo. Además, no tiene efectos secundarios para las células sanas como lo hacen las quimioterapias, publicó la revista Nature, consultada por el portal Muy Interesante.
Esta podría ser una nueva alternativa para combatir el cáncer de sangre e hígado, así como para retrasar la recaída del cáncer.
La investigación, dirigida por Tim Thomas y Anne Voss del Instituto Walter and Eliza Hall, Jonathan Baell del Instituto de Ciencias Farmacéuticas Monash y Brendon Monahan de Cancer Therapeutics CRC, indagaron si la inhibición de KAT6A y KAT6B podría representar un nuevo enfoque para tratar el cáncer.
Se sabe que ambas proteínas - KAT6A y KAT6B- juegan un papel importante en
la conducción del cáncer. KAT6A se encuentra en el número 12 en la lista de
genes más comúnmente amplificados en cánceres.
"Desde el principio, descubrimos que el agotamiento genético de KAT6A cuadruplicaba a esperanza de vida en modelos animales de cáncer de sangre llamado linfoma. Armados con e conocimiento de que KAT6A es un importante factor de cáncer, comenzamos a buscar formas de inhibir la proteína para tratar el cáncer".
Este fármaco, a diferencia de la quimioterapia y radioterapia, ataca directamente a las células cancerosas, y no a las sanas.
"Esta nueva clase de compuestos detienen la división de las células cancerosa desactivando su capacidad de 'activar' el inicio del ciclo celular. El término técnico es la senescencia celular. Las células no están muertas, pero ya no pueden dividirse y proliferar. Sin esta capacidad, las células cancerosa se detienen en seco".